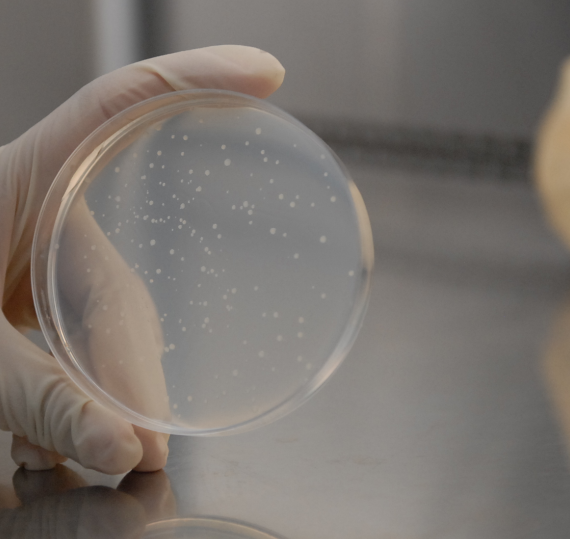
食蟹猴肠微粒体 Monkey Intestinal Microsomes

网站主页
食蟹猴肠微粒体 MONKEY INTESTINAL MICROSOMES
食蟹猴肠微粒体 Monkey Intestinal Microsomes
食蟹猴肠微粒体 Monkey Intestinal Microsomes
Monkey(Cynomolgus) Intestinal Microsomes
¥25
20mg
起订
江苏 更新日期:2026-02-28
产品详情:
- 中文名称:
- 食蟹猴肠微粒体 Monkey Intestinal Microsomes
- 英文名称:
- Monkey(Cynomolgus) Intestinal Microsomes
- 产品类别:
- 1 ADME产品 体外代谢标准品
公司简介
汇智和源是一家专注于亚细胞酶,原代细胞,类器官等生物试剂解决方案的创新型企业,公司围绕原代细胞相关产品,开发了肝溶酶体、肝微粒体/肝S9/诱导肝S9/肝Cytosol、CYP/UGT重组酶等亚细胞酶,原代肝细胞/肾细胞/肺细胞、原代PBMC,SMC等原代细胞及细胞分离、磁珠分选、细胞扩增试剂盒、细胞培养基、冻存液产品,原代肝细胞三明治模型/3D成球、原代肝细胞类器官等类器官产品,为创新药研发体外评价提供关键工具,实现原代细胞等高端生物试剂国产替代。公司累计服务客户超2000家,包括药明康德,康龙化成,昭衍,Sanofi,MERCK,BMS,百济神州,恒瑞医药等知名CRO和创新药企。
| 成立日期 | (8年) |
| 注册资本 | 200 |
| 员工人数 | 50-100人 |
| 年营业额 | ¥ 100万以内 |
| 经营模式 | 工厂,试剂,服务 |
| 主营行业 | 生化试剂,代谢组学,细胞培养,蛋白组学,通用试剂 |
食蟹猴肠微粒体 Monkey Intestinal Microsomes相关厂家报价
-

- 食蟹猴胰高血糖素(GC)elisa试剂盒
- 上海臻科生物科技有限公司 VIP
- 2026-04-22
- ¥2200
-

- 食蟹猴甲状腺激素(Thyroid Hormones)ELISA检测试剂盒
- 上海将来实业股份有限公司
- 2026-04-21
- 询价
-

- 猴肝微粒体
- 江苏齐氏生物科技有限公司 VIP
- 2026-04-07
- 询价